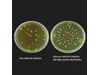

PMS MiniCapt Pro - Remote Microbial Air Sampler
The MiniCapt® Pro Microbial Air Sampler allows the user to perform microbial air sampling in cleanroom environments for viable particle monitoring. The sampler is designed for critical manufacturing environments according to ISO Class 5/7 and GMP Grade A/B and for use in background areas monitored by a Facility Monitoring System (FMS). MiniCapt Pro can be fully integrated into Particle Measuring Systems’ FacilityPro system or other FMS using MODBUS communications. It’s fully compliant with the ISO 14698 standard, and the MiniCapt Pro can be installed with an optional inlet filter between the sampling atrium and the instrument or with an external filter on the exhaust for protection from contaminated air samples.
Streamline your monitoring processes with the MiniCapt® Pro. It incorporates the latest viable cleanroom monitoring technologies into one instrument.
- Optimize cleanroom uptime
- VHP resistant
- Fully compliant with ISO 14698 and EU GMP Annex 1
Built for the most critical environments, it delivers uncompromising protection and compliance.
Fully compliant with ISO 14698, EU GMP Annex 1, and global pharmacopeia standards (USP, EP, JP). Your processes stay audit-ready without compromise.
Seamless integration with FacilityPro® or other FMS systems via MODBUS ensures secure, automated data handling aligned with modern compliance requirements.
- MiniCapt® Pro-E 25
- Flow Rate: 25 LPM
- Power: Power over Ethernet (PoE) for streamlined installation
- Ideal for environments prioritizing minimal cabling and simplified connectivity.
- MiniCapt® Pro-Plus 25
- Flow Rate: 25 LPM
- Power: AC (85–264 VAC) or DC (24 VDC)
- Includes digital I/O for integration with facility systems.
- Perfect for standard cleanroom setups requiring flexible power options.
- MiniCapt® Pro-Plus 100
- Flow Rate: 100 LPM for rapid sampling in high-risk zones
- Same power and I/O flexibility as Pro-Plus 25.
Microbial Air Sampling for viable particle contamination with easy integration into an Environmental Monitoring System
Without measurement there is no control®
The MiniCapt Pro can easily connect to the BioCapt® stainless steel impactor or the BioCapt® Single Use impactor head. Both have precision-cut radial slits ensuring laminar flow, making false positive identification easier, and maximizing collection efficiencies for viable particles in accordance with ISO 14698-1. The versatile and adjustable dimensions of the BioCapt units allow the MiniCapt Pro Sampler to be used with almost every commercially available agar plate.
The MiniCapt Pro can be powered by PoE or via optional 24 VDC or 110-240 VAC power. Options include two digital inputs, three digital outputs as well as the ability to communicate via WiFi with a plug in USB adapter.
Fully Compliant
- ISO, USP, EP, and JP
- In accordance with most recent data management requirements
Precision (BioCapt® and BioCapt® Single-Use)
- Meets ISO 14698-1
- Radial slit design ensures optimal recovery for microorganisms during sampling
- Immediate and easy detection of false-positive results
- Feller correction only above 57 CFU needed, max 3% overlap deviations at 200 CFU
Security
- Remote Sampling ensures low intervention
- No environmental contamination of critical control points with optional HEPA-filtered inlet and exhaust air
- Single Use Sampling method with BioCapt Single-Use reduces risk to the process and the final product
- ISO 14698-1 compliant
- PoE option for simple installation and communications.
- Quick disconnect mounting bracket with optional NFC configuration for simplified installation
- Adjustable height and diameter mechanism for versatile agar dish
- compatibility with BioCapt
- Modern and easy to use data and sample configuration management by integration with the FacilityPro® system or other existing monitoring systems via MODBUS
- Optional DC or AC power along with optional Digital inputs/outputs. Plug in WiFi capability
- Aseptic viable particle environment monitoring
- Monitoring compressed gas
- Remote Isolator sampling
- Use with BioCapt® Single Use for a completely validated solution
- Microbial air sampling of critical control points in cleanrooms and associated controlled environments
- Microbial air sampling in aseptic manufacturing areas (e.g., cleanrooms, isolators, RABS) according to regulations